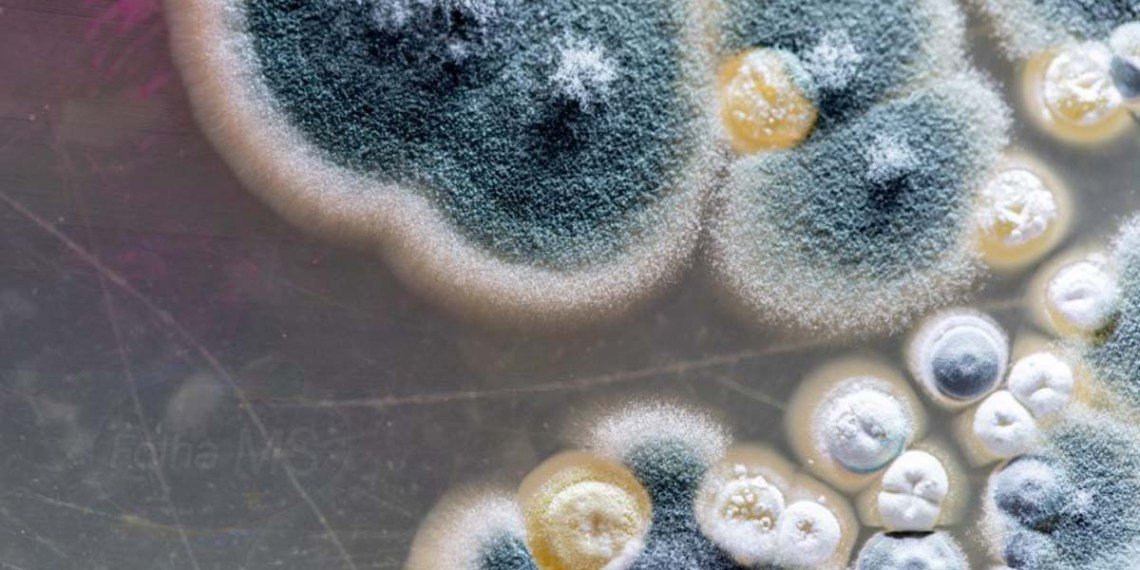

Ao contrário do que foi anunciado neste domingo (6), a suspeita de contágio por fungo negro em um paciente diagnosticado com Covid-19 em Corumbá, não foi descartada.
Segundo informou o Secretário Municipal de Saúde de Corumbá, Rogério Leite, o resultado preliminar teria dado inconclusivo para a Murcomicose.
“Mitologia direta deu inconclusivo eo crescimento em cultura está em andamento para ver se cresce o fungo ou não”, afirmou na manhã desta segunda-feira (7), à reportagem do Folha MS.
A suspeita recai sobre um paciente de 50 anos de idade, internado no Centro de Tratamento Intensivo da Santa Casa de Corumbá após, desenvolver sintomas graves da contaminação pelo novo Coronavírus
A informação é de que o paciente já teria sido imunizado com as duas doses da vacina. Ainda de acordo com a Secretaria Estadual de Saúde, o prazo determinado para o resultado do exame poderia varias de 15 a 30 dias, devido à complexidade do exame.
1º Caso em MS
O primeiro paciente a ser diagnosticado no estado foi um homem de 71 anos de idade, que também já havia sido vacinado com as duas doses do imunizante. No entanto, apresentou os sintomas da doença no dia 18 de maio.
Ele apresentava comorbidades como diabetes e hipertensão e desenvolveu a mucormicose no olho direito e morreu no dia 02 de junho.
Fungo Negro
A mucormicose, conhecida como “fungo negro” é o novo temor associado à covid-19, que se alastrou na Índia, com 9 mil infectados e está em investigação no Brasil, com casos suspeitos em Mato Grosso do Sul, São Paulo, Santa Catarina e Manaus.
A doença necrosa os tecidos da face, atingindo nariz, olhos e podendo chegar ao cérebro. Segundo dados do Hospital das Clínicas de São Paulo, complexas cirurgias são necessárias para salvar o paciente e 50% deles não resistem às complicações.
Fonte: Folha MS